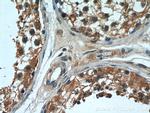
OSBPL9 Antibody in Immunohistochemistry (Paraffin) (IHC (P))
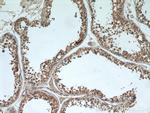
OSBPL9 Antibody in Immunohistochemistry (Paraffin) (IHC (P))

Search
Proteintech
OSBPL9 Polyclonal Antibody
{{$productOrderCtrl.translations['antibody.pdp.commerceCard.promotion.promotions']}}
{{$productOrderCtrl.translations['antibody.pdp.commerceCard.promotion.viewpromo']}}
{{$productOrderCtrl.translations['antibody.pdp.commerceCard.promotion.promocode']}}: {{promo.promoCode}} {{promo.promoTitle}} {{promo.promoDescription}}. {{$productOrderCtrl.translations['antibody.pdp.commerceCard.promotion.learnmore']}}
产品信息
11879-1-AP
种属反应
宿主/亚型
分类
类型
抗原
偶联物
形式
浓度
规格
纯化类型
保存液
内含物
保存条件
运输条件
产品详细信息
Immunogen sequence: DLTKVVLPT FILERRSLLE MYADFFAHPD LFVSISDQKD PKDRMVQVVK WYLSAFHAGR KGSVAKKPYN PILGEIFQCH WTLPNDTEEN TELVSEGPVP WVSKNSVTFV AEQVSHHPPI SAFYAECFNK KIQFNAHIWT KSKFLGMSIG VHNIGQGCVS CLDYDEHYIL TFPNGYGRSI LTVPWVELGG ECNINCSKTG YSANIIFHTK PFYGGKKHRI TAEIFSPNDK KSFCSIEGEW NGVMYAKYAT GENTVFVDTK KLPIIKKKVR KLEDQNEYES RSLWKDVTFN LKIRDIDAAT EAKHRLEERQ RAEARERKEK EIQWETRLFH EDGECWVYDE PLLKRLGAAK H (209-558 aa encoded by BC025978)
靶标信息
This gene encodes a member of a subfamily of LIM domain proteins that are characterized by an N-terminal proline rich region and three C-terminal LIM domains. The encoded protein localizes to the cell periphery in focal adhesions and may be involved in cell-cell adhesion and cell motility. This protein also shuttles through the nucleus and may function as a transcriptional co-activator. This gene is located at the junction of certain disease related chromosomal translocations which result in the expression of chimeric proteins that may promote tumor growth. Alternate splicing results in multiple transcript variants.
仅用于科研。不用于诊断过程。未经明确授权不得转售。
生物信息学
蛋白别名: FLJ12492; FLJ14629; FLJ14801; FLJ32055; FLJ34384; MGC15035; ORP-9; OSBP-related protein 9; OSBP4; OSBPL9; Oxysterol-binding protein-related protein 9; RP4-657D16.1; unnamed protein product
基因别名: 2600011I06Rik; AU015843; ORP-9; ORP9; OSBP4; OSBPL9
UniProt ID: (Human) Q96SU4, (Mouse) A2A8Z1
Entrez Gene ID: (Human) 114883, (Mouse) 100273